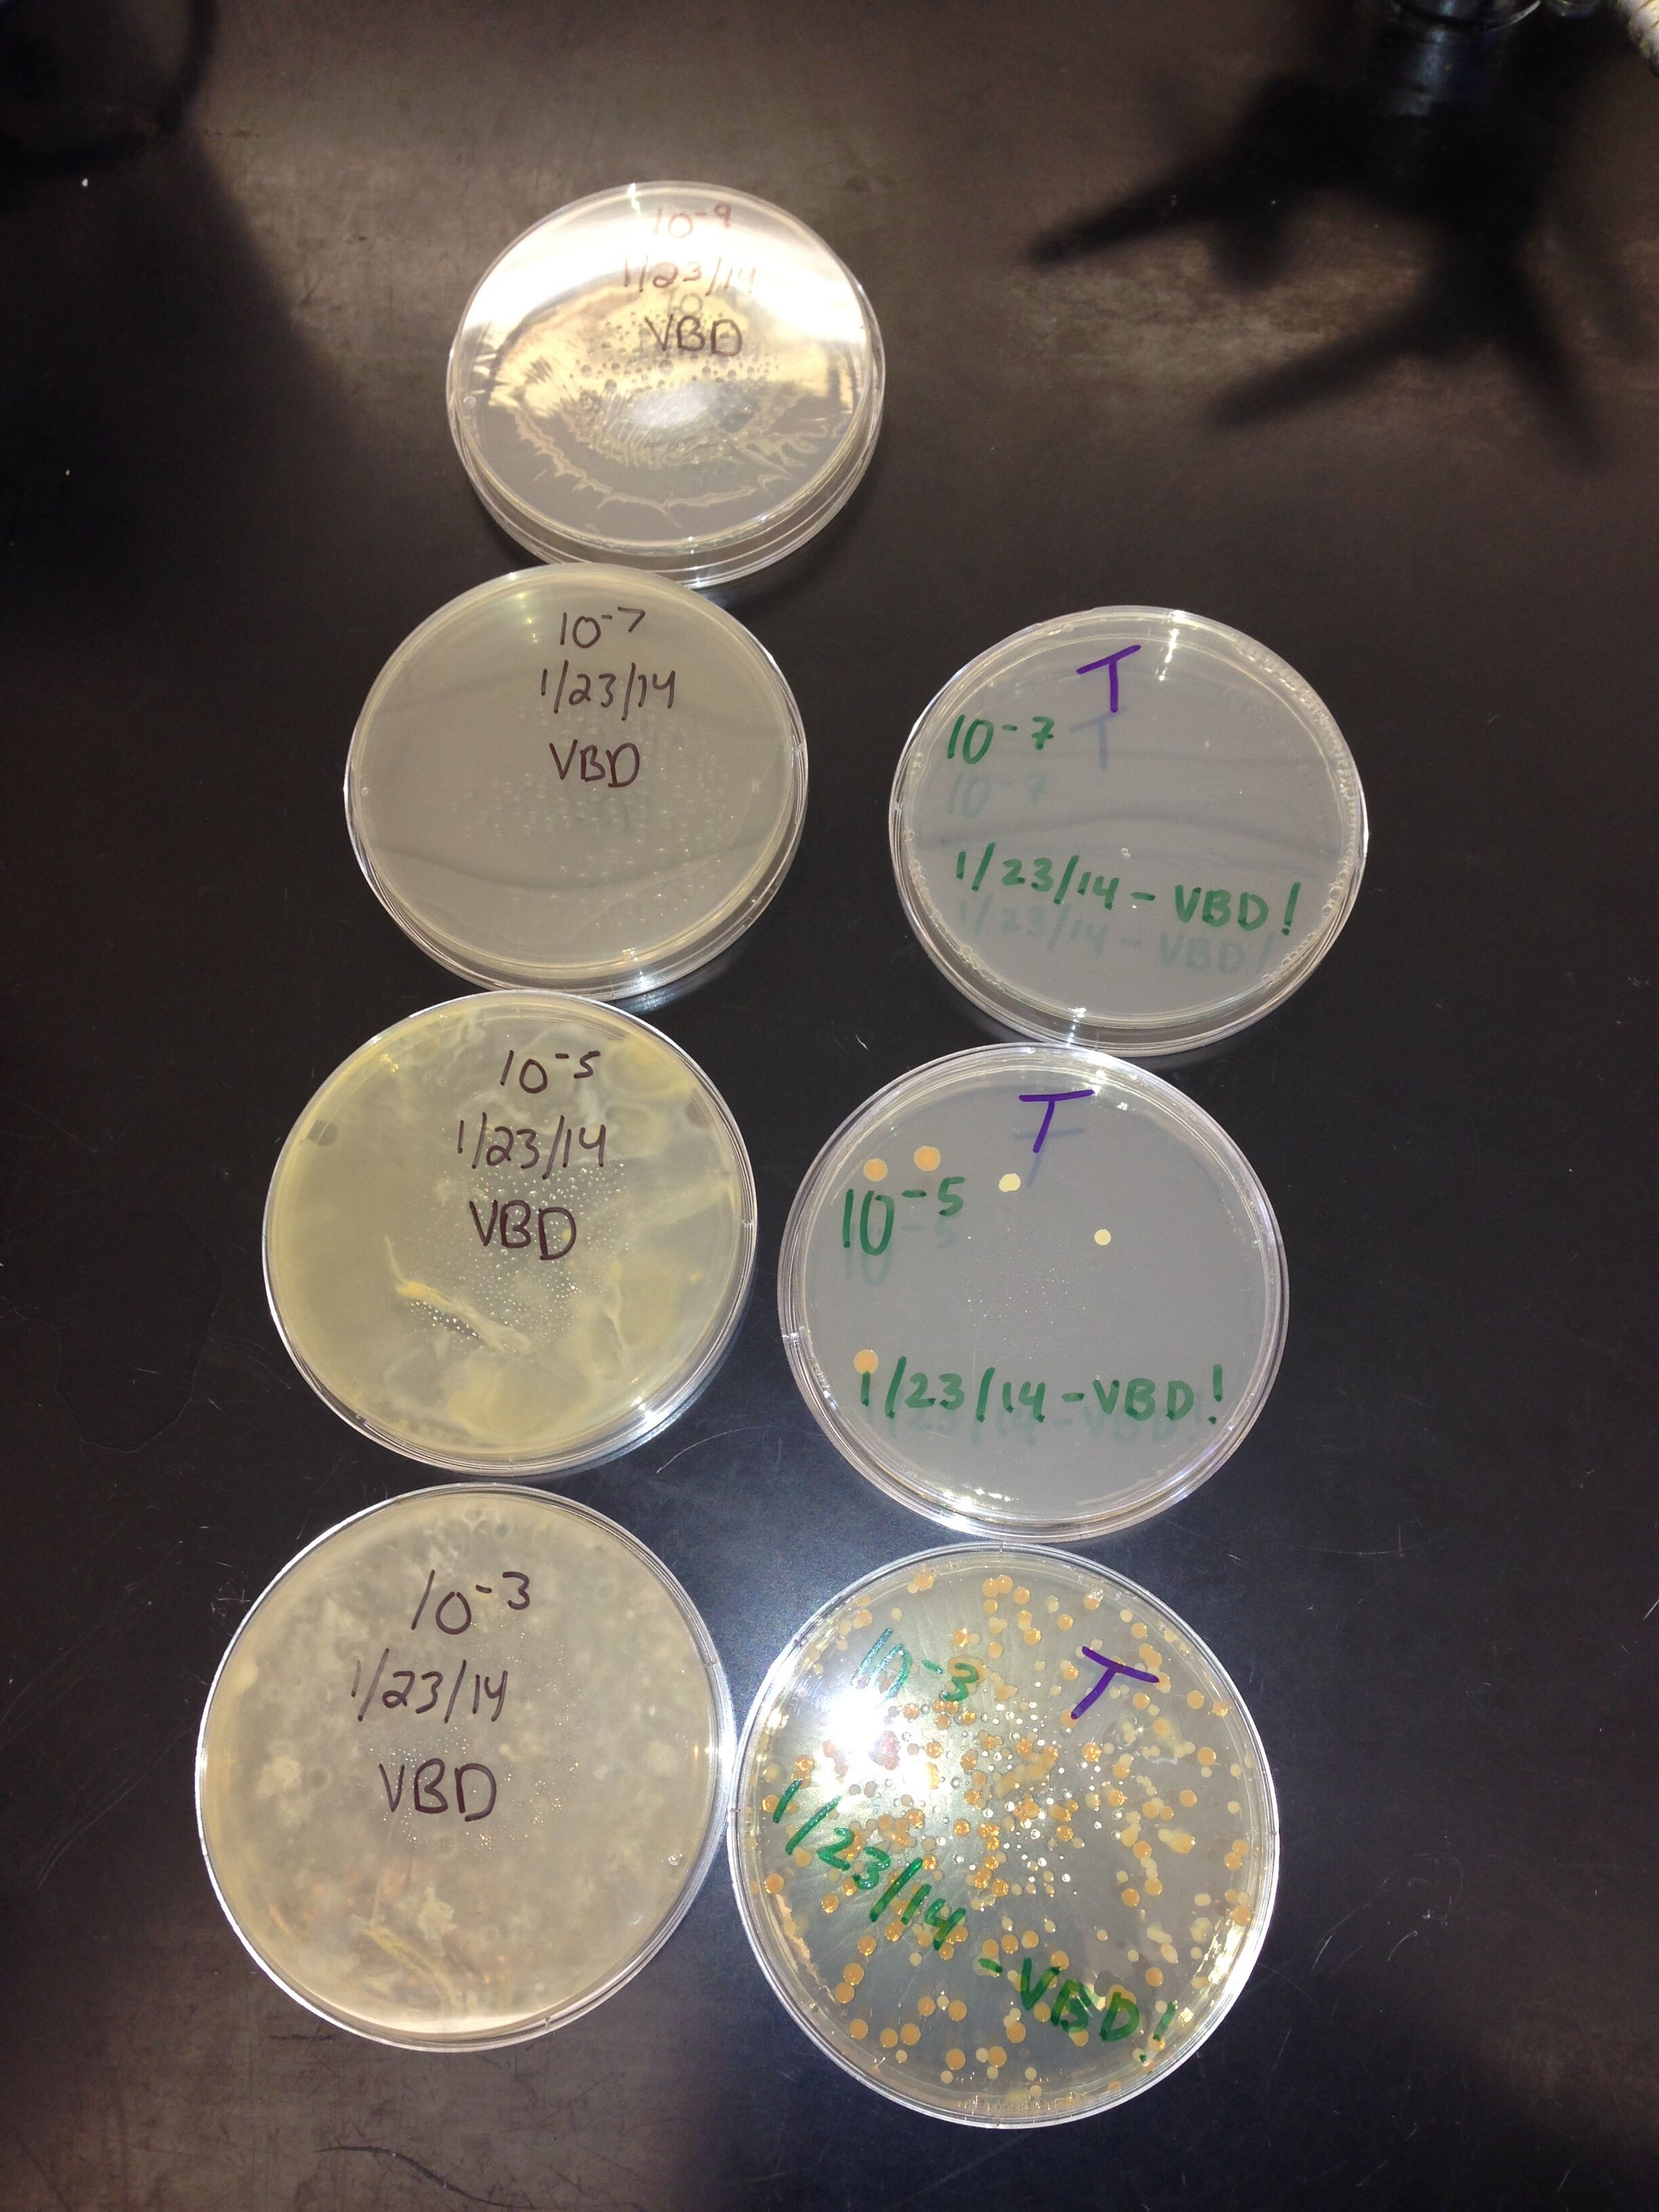

User:David Kowalski/Notebook/Biology 210 at AU
"March 23" Within 14 days, all the zebra fish had died. At day 12, all the fish in the control solution had died while there were three alive in the 1% and four alive in the 2%. Some zebrafish were treated and their body part size were documented. On average, the eyes and the heads of the fish in the alcohol solutions were larger, as predicted in the article we read earlier in the semester. many of the zebrafish died off within the fish week. The ones who did survive into the second week had swimming problems. Surprisingly, many of the fish in the control died faster than those in the alcohol solutions. DK
March 7 Last week we received the identification of the bacteria from our trasncet. The first one from the 10^-3 nutrient petri dish was unidentifiable. The second one from the 10^-3 tet petri dish was pseudomonas. The third bacteria sample from the 10^-5 tet petri dish was sphingobacterium faecium. DK
February 23 On Friday, I checked to see how our three samples of zebrafish embryos were doing. The 20 embryos in the control sample were still alive and had the features and size of a 31-36 year old zebrafish embryo. That was accurate because it had only been approximately 24 hours since we last checked the zebrafish. When we initially but them into their environments, they all looked to be between the age of 11 and 16 hours, so if you add 24 hours to that, you get around 36 hours old. Out of the 20 embryos in the 1% ethanol solution, only four embryos had died and were removed. The other embryos alive looked to be between 31-36 hours old. Out of the 20 embryos in the 2% ethanol, only one had died and the 19 others looked to be between the age of 31-36 hours old. No water was added to the three petri dishes because not a lot of water had evaporated.
February 20 Unfortunately, last week we were unable to have our invertebrate lab so this week we played catch up. We observed the invertebrates that entered our funnel full of ethanol. We saw four different species from our transect, two soil mites, one spring tail (primitive insect), one spring tail, and two proturan (primitive). This shows that many different types of invertebrates live in our trasect that are not observable with our naked eye. After observing our invertebrates from our transect, we took a look at some prepared, larger animals. A bubble bee, spider, millipede, centipede and baby crab. All these animals were dead but were still helpful in identifying features unique to certain types of invertebrates. After that bit about invertebrates, we moved onto embryology and zebrafish development. Britney and I researched the effects of zebrafish development and alcohol in preparation for the lab. We gave a quick summary of the test conducted before with regard to physical deformities caused because of alcohol in the breeding water of zebrafish. After the presentation, we prepared our sample petri dishes with pure water, 1% ethanol solution and 2% ethanol solution to observe the effects of alcohol on zebrafish. We decided to add a second determination of 2% ethanol because in the paper we researched before class, it showed that although there were zebrafish that lived in 1.5% ethanol after day seven, there were zero fish that survived in a 2.9% ethanol solution after seven days. Britney and I are trying to determine the threshold were the zebrafish can still grow into adults, with physical defects, in a certain amount of ethanol in their environment. Hopefully 2% ethanol will be an appropriate amount and we can gain some information as to how much is too much for zebrafish development. We put the fish eggs in their respective petri dishes and determined that they all feel in between the age of 11-16 hours. Tomorrow, Friday, February 21, I will observe any changes that occurred over the last 24 hours with the zebrafish in all environments and take notes on any physical changes in the embryos. We took out any dead embryos from the three environments and have 20 embryos in each.
February 6 We went back to our transects and took plant samples from trees, bushes and plants. We also observed fungi under the microscope from prepared samples. Plant 1: From back of transect. Big tree, little branch. Dicot, angiosperm. Has vascularization. Leaves: needles on side of oval shaped leaf. Red berries with seeds inside. American Holly tree? Plant 2: From back of transect. under tree. Big leaves, medium sized bush. Has vascularization. Dicot, veiny leaves, smooth edges. No flowers or reproduction. Gymnosperm. Pant 3: covers 78% of transect. Low dead/brown short plant. Has vascularization. Veiny and smooth edged leaves. No flowers or reproduction. Gymnosperm. Plant 4: Covers front/middle part of transect. Smelly, low lying dead plant. Has vascularization. Looked burnt orange rusty color. Dried out. No flowers, dicot, gymnosperm. Plant 5: MIddle of transect. Few branches and leaves alive, but flowers are dead. Tall bushes. Has vascularization. Green leaves. Dead flower buds, angiosperm. We took a final look at our culture from our transect. It was very empty because a lot of water evaporated. We prepared a funnel with plant matter in it so that next week we can see a preservation of animals at the bottom of the flask. We will look at the animals under a microscope to observe their features and see what makes them different from plants, bacteria and protists. DK
January 30 Today in lab we looked at our bacteria samples of different concentrations and how much they grew in agar plates and in agar plates with antibiotics. We wanted to see how bacteria colonies grow when placed in a different environments and use the cultured bacteria to observe the characteristics of bacteria. To do this, we first took a bit of the bacteria sample from three samples that had a lot of bacteria cultures in them. We then swabbed out bacteria, smeared it on a slide and observed the organisms. Then we took another swab of bacteria and gram stained it and found out that only one section was gram positive, the one labeled VK 10^-3 T. We finally prepared a sample of the bacteria and amplified the 16S gene of the bacteria. Next lab we will put our three samples of the 16 S gene in a gel electrophoresis to see if our bacteria samples were real. VK10^-3 T: bacteria colony was circular, yellow/orange, convex and entire. Gram positive. BN10^-5 T: bacteria colony was orange, circular raised and undulated.No motility. Rod and segmented short diplobacilli. Gram negative DK10^-3: bacteria colony was gray/biege, irregular, undulate and raised. A lawn of staphylocus, circular bacteria with flagella. Gram negative. This lab prepared us for next week when we observe the bacteria gene. DK
January 24, 2014 This week in lab we checked out our culture that contains dirty, soil, tree branches and leaves from our transect. We observed two different sample of our culture:one from the water's surface that had a film on it and a sample from the very bottom, right above the sand and soil. There was no overpowering smell when we lifted the lid off the jar. There were very few organisms living at the surface of the water while there were many bacteria at the bottom of the water sample, near the soil. If the culture was observed for another two months, one would expect to see more and more bacteria to form in more parts of the jar, not just at the bottom of the culture near the soil. DK
January 22, 2014 This was the first day of the Biology lab and today we were introduced to our transect. The link to a picture of our transect is posted below. We had to document all things that are part of the transect, whether living or nonliving. We noted the location of buildings and trees and how that might effect sunlight, the water supply for the transect, and protect from humans and the campus life. This transect is unique due to the amount of diverse plants in the given area. It is also quite isolated from most of the people occupying the campus. After diagraming and noting everything in our transect, we took a sample of the soil, leaves and branches in a tub. The point of that was to keep some bacteria alive for a week and allow them to grow so we can observe them next week.
https://mail.google.com/mail/u/0/?ui=2&ik=e824392fa9&view=att&th=143d63232576d0ca&attid=0.0&disp=safe&zw
Location: Tall Bushes next to Bender Arena and above the Amphitheater. Area is blocked in by two pathways. Three or four different types of bushes. The area is shaded by Bender arena some times during the day. At the time of our visit, half of the area was in the sun and the other was not. Around the area, other tall green bushes to protect it from wind and people.
Abiotic: (2) light posts, (2) sprinkler heads, pathway/stones, trash, cigarette butt Biotic: Short brown plants, Tall empty plants, bacteria, weeds, squirrel DK